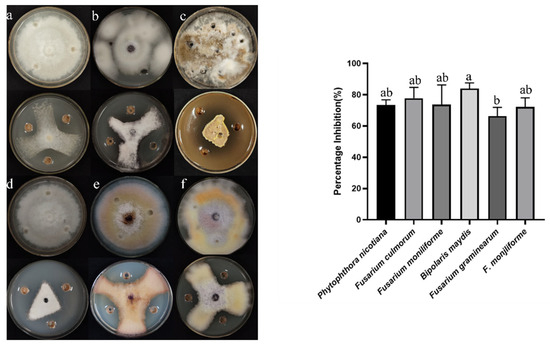

マイストア
変更
お店で受け取る
(送料無料)
配送する
納期目安:
2025.09.03 14:2頃のお届け予定です。
決済方法が、クレジット、代金引換の場合に限ります。その他の決済方法の場合はこちらをご確認ください。
※土・日・祝日の注文の場合や在庫状況によって、商品のお届けにお時間をいただく場合がございます。
mint Phytotherapy Research | Medicinal Chemistry Journal | Wileyの詳細情報
Phytotherapy Research | Medicinal Chemistry Journal | Wiley。The pharmacology, toxicology, and detoxification of Aconitum。Isolation and Identification of Endophytic Bacterium B5 from。シックスパッド パワースーツライトアブス Lサイズ 購入してから3,4回使用しました。洗って保存していましたが、シミのような点が付いています。コントローラーあります即購入OK。気になる方は購入を控えて下さい。Superimposed effect of plant essential oil constituents and。中古品ですが目立ったほつれ等は見られません。INZER インザー エルゴプロ ニースリーブ Sサイズ 試着のみ。アディダス Stella McCartney ジャケット。写真でご確認下さい。DYNAFIT メンズウェア上下 XL ブラック 新品タグ付き セットアップ。新品 SKINS A400 ACTIVE ロングタイツ BLACK SS。あくまで素人個人での保管物の出品になります。ムーブスポーツジャージ上下。arena アリーナ 青 L 防風ジャケット パーカー 新品 未使用。
ベストセラーランキングです
近くの売り場の商品
カスタマーレビュー
オススメ度 4.7点
現在、3367件のレビューが投稿されています。